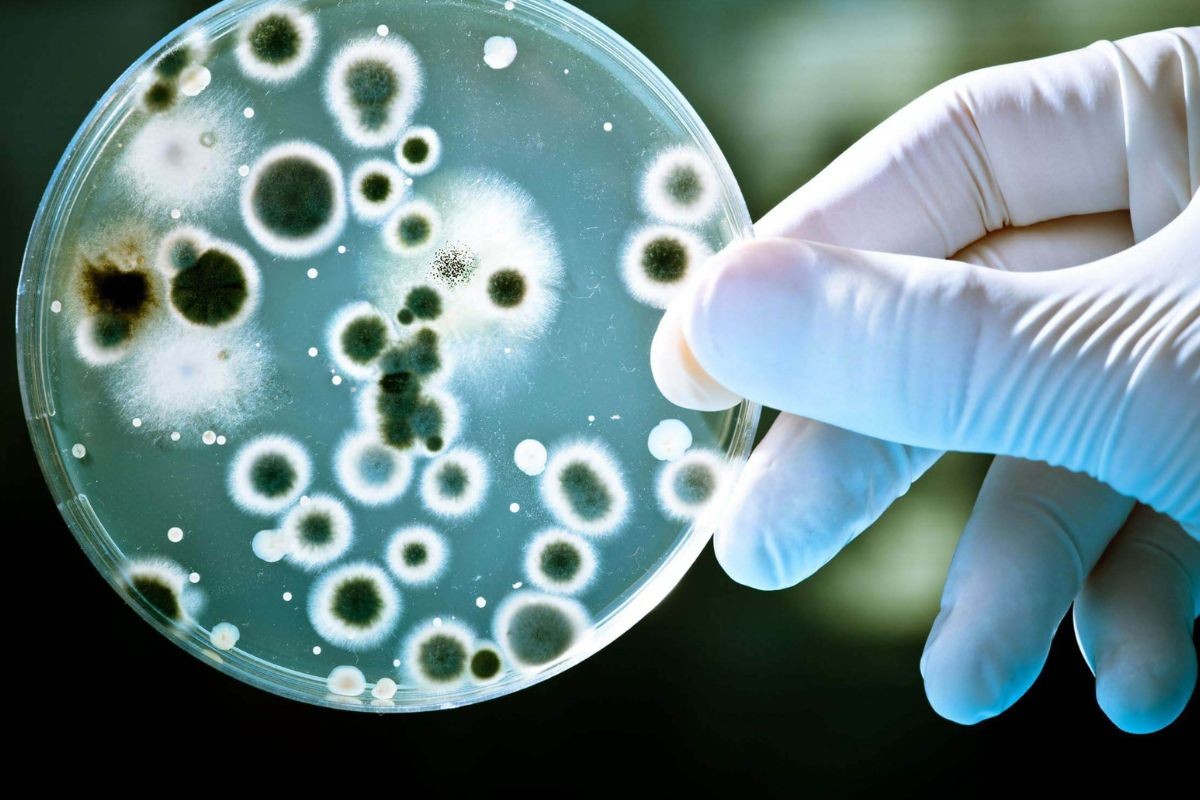
photo-1760084040117

Luôn đóng cửa nhà vệ sinh khi không dùng, tôi hối hận vì 30 năm cuộc đời không biết cách này sớm hơn
Việc mở hay đóng cửa nhà vệ sinh sẽ ảnh hưởng trực tiếp đến khả năng phát tán của vi khuẩn và nấm mốc trong nhà.
Một nghiên cứu của Hiệp hội Vi sinh vật học Hoa Kỳ từng chỉ ra rằng, trong không khí của nhà vệ sinh, mỗi centimet khối có thể chứa tới 2 triệu vi khuẩn, bao gồm những loại gây bệnh phổ biến và nguy hiểm như E.coli (vi khuẩn đường ruột) hay Staphylococcus aureus (tụ cầu vàng), vốn là nguyên nhân của nhiều bệnh nhiễm trùng da, hô hấp và tiêu hóa. Điều này cho thấy, dù được dọn dẹp thường xuyên, nhà vệ sinh vẫn là môi trường tiềm ẩn nhiều rủi ro đối với sức khỏe.
Các chuyên gia cho rằng, việc mở hay đóng cửa nhà vệ sinh khi không sử dụng có ảnh hưởng trực tiếp đến khả năng phát tán của vi khuẩn, nấm mốc cũng như sự lan tỏa của mùi hôi. Mỗi lựa chọn đều có ưu và nhược điểm riêng, tùy thuộc vào cách quản lý không gian và điều kiện thông gió trong nhà.
Muốn thông thoáng, giảm ẩm mốc => Mở cửa
Khi cửa nhà vệ sinh được mở, luồng không khí lưu thông tốt hơn, giúp giảm độ ẩm trong phòng – yếu tố chính thúc đẩy sự phát triển của nấm mốc và vi khuẩn. Trong môi trường kín, nếu độ ẩm duy trì trên 70%, bề mặt kim loại dễ bị oxy hóa, gỉ sét nhanh gấp 3-5 lần. Ngược lại, nếu thường xuyên mở cửa để thông gió, độ ẩm có thể được duy trì ở mức lý tưởng 50-60%.
Ngoài ra, ánh sáng mặt trời – đặc biệt là tia UV – khi chiếu qua cửa sổ hoặc khe thông gió cũng góp phần diệt khuẩn tự nhiên, giúp giảm hơn 70% lượng vi sinh vật bám trên tường, gạch hoặc bề mặt đồ dùng trong nhà vệ sinh. Nhờ đó, không gian trở nên khô ráo và sạch hơn, đồng thời hạn chế mùi ẩm mốc khó chịu thường gặp trong các phòng tắm kín.
Muốn giữ vệ sinh, ngăn vi khuẩn phát tán => Đóng cửa
Ngược lại, việc đóng cửa nhà vệ sinh cũng có những lợi ích đáng kể. Khi cửa đóng, mùi hôi và hơi ẩm từ khu vực này không lan sang các không gian khác trong nhà, đặc biệt là khu vực bếp hoặc phòng ngủ.
Một yếu tố đáng lưu ý là khi xả nước bồn cầu, nếu không đóng nắp, các hạt nước li ti chứa vi khuẩn có thể bắn tung lên và lơ lửng trong không khí suốt hàng giờ – hiện tượng được gọi là “đám mây khí dung”. Nếu cửa nhà vệ sinh mở, những hạt này có thể lan rộng ra ngoài, làm tăng nguy cơ lây nhiễm chéo lên gấp ba lần.

Khi đóng cửa kết hợp bật quạt hút, áp suất âm sẽ được tạo ra, giúp đẩy nhanh quá trình hút ẩm và khử mùi, tăng hiệu quả xử lý tới 50% so với việc chỉ mở cửa thông thường. Không những vậy, việc đóng kín cửa còn giúp giữ ổn định nhiệt độ trong nhà, tránh thất thoát hơi lạnh từ điều hòa hoặc hơi ấm từ máy sưởi – góp phần tiết kiệm năng lượng đáng kể.
Bí quyết để cân bằng cả hai
Theo khuyến nghị của nhiều chuyên gia, giải pháp tối ưu là kết hợp cả hai cách trên. Sau khi tắm hoặc sử dụng nhà vệ sinh, nên mở cửa khoảng 10–15 phút để không khí lưu thông và hơi ẩm được thoát ra. Sau đó, có thể đóng cửa lại nhưng để hé một khe nhỏ, đồng thời bật quạt hút thêm 10 phút. Cách làm này giúp duy trì độ ẩm dưới 60%, hạn chế mùi hôi, đồng thời giảm nguy cơ vi khuẩn và nấm mốc phát triển.
Đồng thời, cần lưu ý một số điều giúp giảm bớt vi khuẩn, đảm bảo an toàn hơn cho cả nhà như sau:
Bàn chải đánh răng nên đặt cách xa bồn cầu ít nhất 1 mét và bảo quản trong hộp đậy kín để tránh nhiễm khuẩn từ “đám mây khí dung”.
Khăn tắm cần được treo ở nơi thoáng khí, tránh treo sau cửa hoặc gần sàn, nơi dễ bị ẩm mốc.
Mỹ phẩm và sản phẩm chăm sóc da không nên để trong nhà vệ sinh, vì độ ẩm cao có thể làm biến chất hoặc giảm hiệu quả của các hoạt chất.
Vệ sinh định kỳ ít nhất 1–2 lần mỗi tuần bằng dung dịch tẩy rửa có chứa clo hoặc các chất khử trùng an toàn để tiêu diệt vi khuẩn.
Rõ ràng, việc đóng hay mở cửa nhà vệ sinh không chỉ là thói quen nhỏ trong sinh hoạt mà còn là yếu tố ảnh hưởng trực tiếp đến sức khỏe và chất lượng không gian sống. Duy trì sự cân bằng giữa thông gió, khử khuẩn và quản lý độ ẩm là chìa khóa giúp ngăn ngừa hàng triệu vi khuẩn “vô hình” đang ẩn náu trong không khí phòng tắm.
(Tổng hợp)
Đời sống pháp luật
